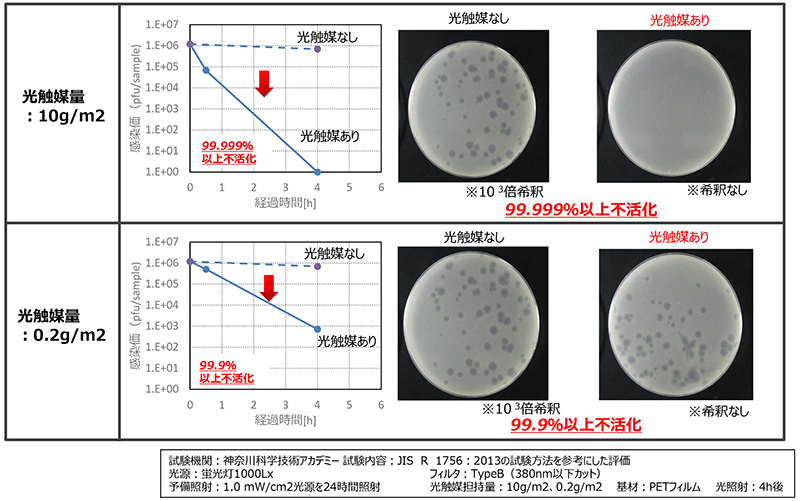
ThreeBond6735 抗ウィルス効果

可視光応答型光触媒スプレー 全量噴射タイプ
ThreeBond 6735 は、酸化タングステンという光触媒が太陽光はもちろんのこと、LEDを使用した車内灯などの目に見える僅かな光との作用により、高い消臭・抗菌効果、更には抗ウィルス効果が長期間得られます。
【製品名】可視光応答型光触媒スプレー 全量噴射タイプ ThreeBond6735
【主成分】酸化タングステン
【用 途】自動車室内専用消臭・抗菌・抗ウィルス スプレー
【内容量】86ml ※1台使い切りタイプ
【消防法】非危険物 火気厳禁
【高圧ガス保安法】高圧ガス:DME使用 火気と高温に注意 車内持込厳禁
TB6735商品チラシ
【主成分】酸化タングステン
【用 途】自動車室内専用消臭・抗菌・抗ウィルス スプレー
【内容量】86ml ※1台使い切りタイプ
【消防法】非危険物 火気厳禁
【高圧ガス保安法】高圧ガス:DME使用 火気と高温に注意 車内持込厳禁
TB6735商品チラシ
製品特長
- 酸化タングステンという光触媒が可視光(LEDライトも含む)との作用により消臭・抗菌・抗ウィルス効果を発揮します。
- ワンプッシュで噴射レバーが固定できるため、施工に手間が掛かりません。
- 優れた効果の持続性により、施工後でも発生する臭いの元を分解します。
- 光触媒工業会の自主安全規格に適合しているため、人体への安全性に配慮した設計です。
- 非危険物に該当するため、消防法の規制を受けません。

※酸化タングステンは半永久的に光触媒効果を発揮しますが、人や荷物の出入りにより、有効成分が車外に持ち出されることで、効果は徐々に弱くなります。
酸化タングステンのメカニズム

- 酸化タングステンによりUVカットガラス/LEDライトなどの装備車への対応が可能に。
- 目に見える光やLEDの明かりで知らないうちに消臭・抗菌・抗ウィルスが可能に。
- 「空気の安全・安心」をご提供
ThreeBond6735 消臭効果
白色LED1000lx下において、様々な有臭、有毒ガスの分解を確認

ThreeBond6735 抗菌効果
黄色ブドウ球菌、大腸菌に対して、蛍光灯下24h後の除去率:99.99%以上と高い抗菌力を示した。

ThreeBond6735 抗ウィルス効果
バクテリオファージQβ(ウイルス代替)に対して光照射(4h)することにより、光触媒量0.2g/m2:99.9%以上不活化、光触媒量10g/m2 :99.999%以上不活化と、高い抗ウイルス性を示した。
光触媒工業会の自主安全規格について
光触媒工業会の推奨する4項目について、外部機関で試験を行い、安全性に問題ないとの結果を得ています。

上記の結果より、今回の製品の実使用シーンにおいて、子供が誤飲した場合においても問題になることはないと考えます。
◆ラットを用いた急性経口毒性試験における2000mg/kgは、
⇒体重10kgの子供の場合、20gの光触媒材料を一気に体内に入れた場合に相当。
⇒TB6735のスプレー缶40本以上分を一気に誤飲した場合に相当。
⇒最も極端なケースを想定しても起こりえないため、安全性に問題はないと考えます。
ThreeBond6735 使用量
自動車室内空間の大きさにより、使用本数が変わります。
室内空間4㎥につき1本が目安で、ボックスタイプミニバンクラス等は2本使用となります。
<車両サイズ別 使用量の目安>

使用方法 (事前準備)
- 室内の荷物、特に動物、植物、食べ物は必ず室外へ出してください。
- 窓・ドア・リアゲートを全て閉め、必ずエンジンを停止し、キーを抜いてください。
※本商品は火気厳禁です。
※本商品はエアコンファンの力で室内に噴霧するタイプではありません。必ずエンジンを停止した状態で使用してください。
※ナビ・オーディオ等の機器にはウエスをかぶせるなどして、直接ミストが当たらないようにしてください。 - 座席シートなどに直接噴射ミストがあたらないように、前席を前にスライドして背もたれを前方に起こし、後席の足元床面に設置してください。

- 3列シート車で2本使用する場合 -
2列目シートを前方に起こし、3列目シートの足下床面に設置してください。
ただし、安定した床面と噴射方向に十分な空間が確保できない場合は、3列目シートをたたみトランク中央に設置してください。
使用方法 (施工方法)
- 容器をよく振ってからキャップを外し、噴射レバーを「カチッ」という音がするまで押し下げて、設置場所に置いてください。

- 噴射レバーが固定され噴射状態になったら、直ちに室外に出てドアを閉めてください。
- 噴射時間は約3分で、自動車室内は霧状態になりますので、噴射終了後は定着のため5分間そのままの状態でお待ちください。
- 自動車のすべてのドアを開け、約3分間室内の空気を入れ換えてください。
使用方法 (施工時間)

使用上の注意
使用前に缶をよく振ってから施工を行ってください。
振らずに使用すると噴射不良の原因となります。- 使用前に自動車室内を清掃する場合は、必ず濡れ拭きを実施してください。
- 万が一、施工後樹脂部品が白化がみられた場合は直ちに濡れ拭きを実施してください。
- 噴射ミストが直接あたらないようにしてください。シミの原因になります。
※座席シートを後方に倒し、なるべく空間を確保し、天井から離れた床面に設置してください。
(天井まで1m以上ある場所に設置してください。)
※シートの上には設置しないでください。 - 使用環境により、フロントガラスやダッシュボードが薄く曇ることがあります。
この場合は、濡れタオルやTB6701C(ウエットワイパー) 等を使用して拭き取ってください。
※低湿度の時や、真夏に直射日光でダッシュボードが熱くなっている時、まれに起こる可能性があります。 - 噴射ミストを直接吸わないでください。

- 炎や火気の近くで使用しないでください。※火気厳禁
- 飲み込んだり、吸い込んだり、直接眼や皮膚に触れないようにしてください。
保護眼鏡、保護手袋、保護マスクなどの適切な保護具を着用してください。




